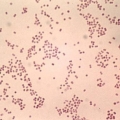
Менингококковая инфекция

Менингококковый менингит, описание симптомов болезни, профилактика, причины, последствия болезни и ее лечение
Описание - Менингококковый менингит

Латинское название: Meningitis
Синонимы: Менингеальные инфекции, эпидемия менингита, инфекция менингококковая, бессимптомное носительство менингококков, менингококконосительство, менингококковая инфекция
Это острое инфекционное заболевание, возбудителем которого является бактерия – Neisseria meningitidis . Имеет большой диапазон клинических проявлений. Чаще всего локализуется и размножается в слизистой оболочке носоглотки.
Описание заболевания - Менингококковый менингит:
ЛЕЧЕНИЕ И ПРОФИЛАКТИКА
- Брилид®
- , Ровамицин®
- , Спирамицин-веро
- , Цефабол®
- , Цефтриабол®
- , Эргоферон
- , Эпоцелин
- , Тимактида таблетки 0,00025 г
- , Терцеф
- , Тамицин
- , Сульфадиметоксина таблетки
- , Сультасин®
- , Сульперазон
- , Стандациллин
- , Рулид®
- , Роксимизан
- , Рифамор
- , Рифадин
- , Римактан
- , Реоглюман
- , Реаферон-ЕС
- , Тобрацин-АДС
- , Фарциклин
- , Ципробрин®
- , Цефурабол®
- , Цефтриаксон-АКОС
- , Цефтидин
- , Цефтазидим-АКОС
- , Цефотаксим Лек
- , Цефосин®
- , Цефоперабол®
- , Цефобид
- , Цефантрал
- , Цефаксон
- , Целестон®
- , Р-цин
- , Полисахаридная менингококковая вакцина А+С
- , Пициллин
- , Ампициллин Иннотек
- , Ампициллин
- , Амоксициллин
- , Амоксисар®
- , Амикацин
- , Иммуноглобулин человека нормальный
- , Зетсил
- , Дардум
- , Гентамицин
- , Гарамицин
- , Веро-Рокситромицин
- , Бруламицин®
- , Акт-ХИБ
- , Акридерм® СК
- , Ампициллин-АКОС
- , Ампициллина натриевая соль
- , Пефлацине
- , Пентрексил
- , Пенодил
- , Пенициллин G натриевая соль
- , Офлоксацин
- , Оспамокс®
- , Метронидазол-АКОС
- , Меронем®
- , Лифоран
- , Ликацин
- , Кламосар®
- , Кетоцеф
- , Канамицина сульфат
- , Вицеф®
- , V-Пенициллин Словакофарма
- .
Специальности по данному заболеванию
Врачи, занимающиеся данным заболеванием
-
 Морозова Марина Александровна Город: Новый Уренгой Опыт: 26 лет
Морозова Марина Александровна Город: Новый Уренгой Опыт: 26 лет
Работаю врачом-терапевтом в коммерческой поликлинике "Сканер" г. Новый Уренгой. Закончила Астраханский государственный медицинский институт в подробнее...




 Налбандова Дарья Аркадьевна Город: Москва Опыт: 1 год
Налбандова Дарья Аркадьевна Город: Москва Опыт: 1 год
В 2006 году окончила Московскую Медицинскую Академию имени И.М. Сеченова. Склонна к безграничному разитию и подробнее...
-




 Фефелова Ирина Викторовна Опыт: 40 лет
Фефелова Ирина Викторовна Опыт: 40 лет
Фефелова Ирина Викторовна- терапевт-гематолог консультант высшей квалификационной категории, кандидат медицинских наук, классический гомеопат. В 1979 г подробнее...